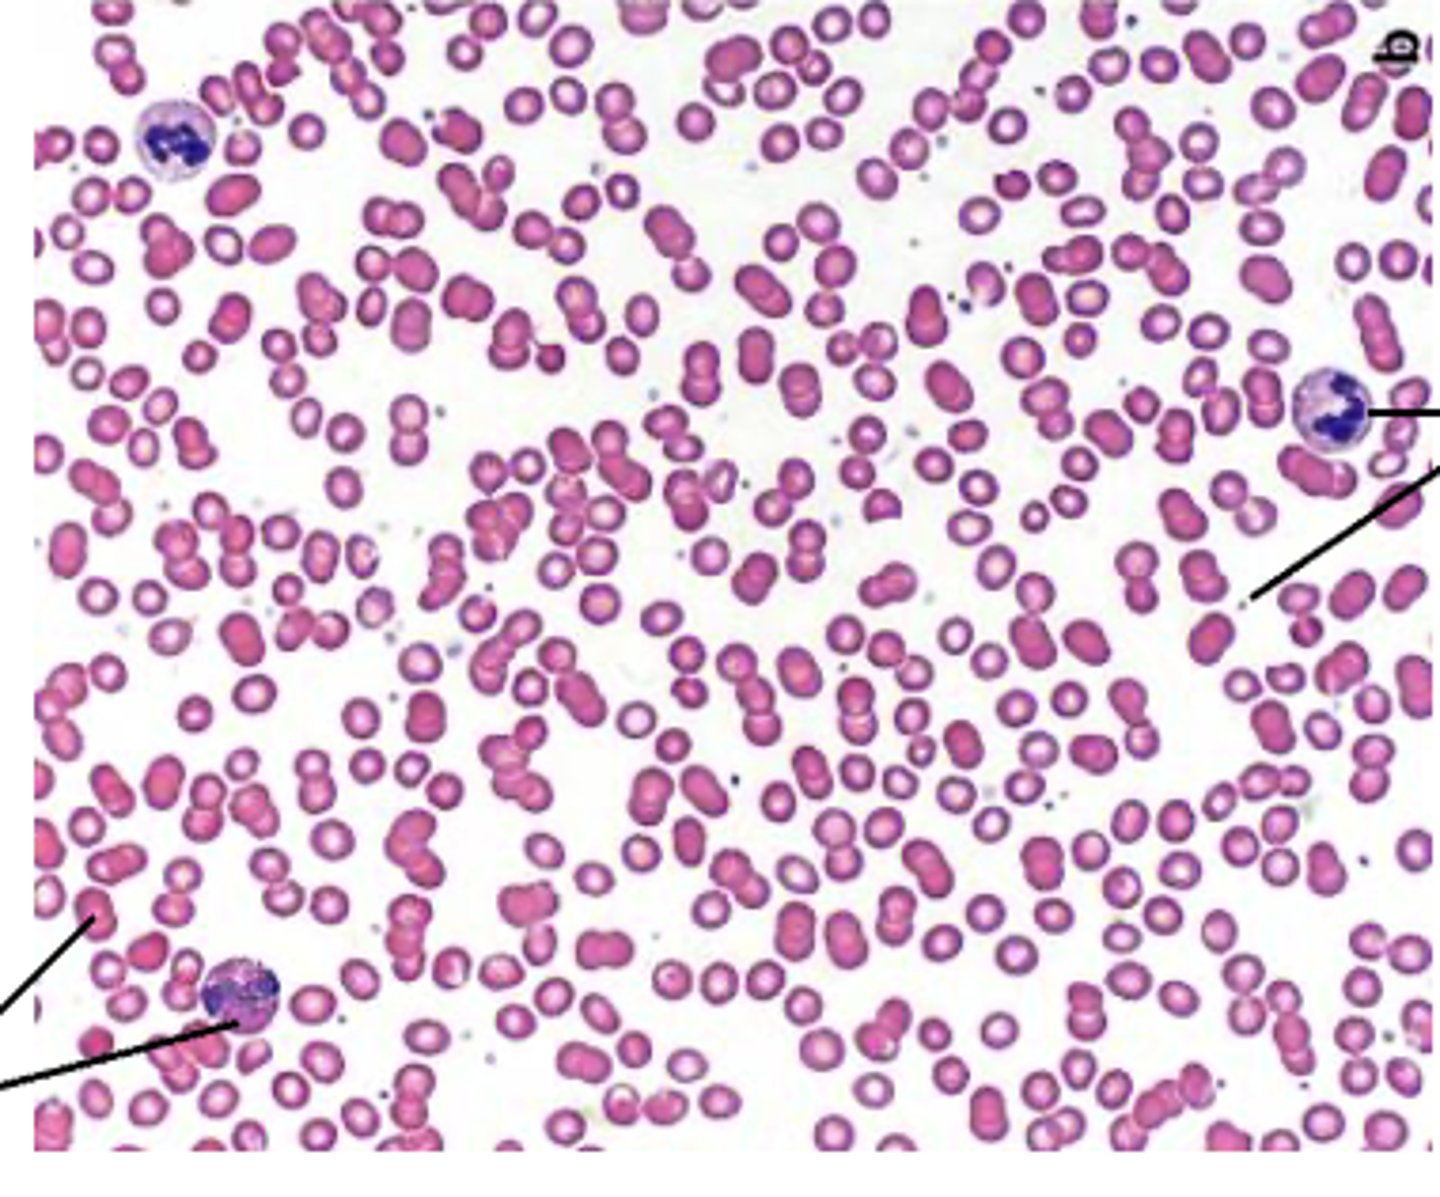
<p>What type of stain?</p>
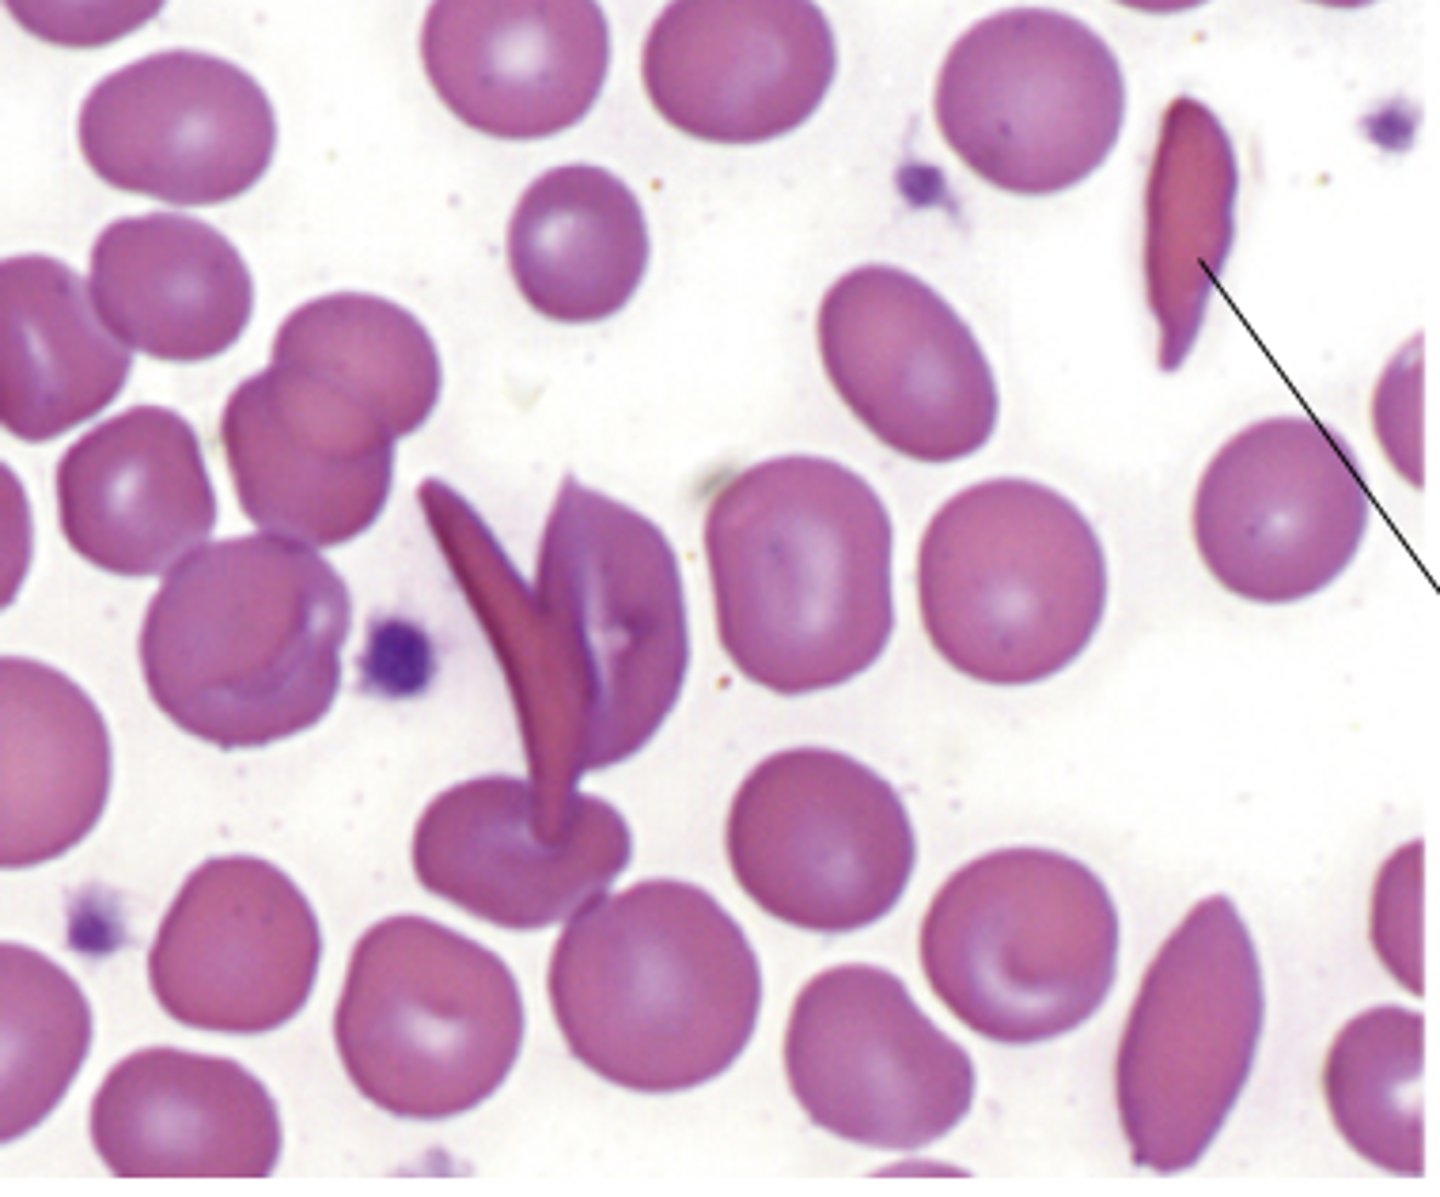
<p>What disease is caused by the abnormal cells?</p>
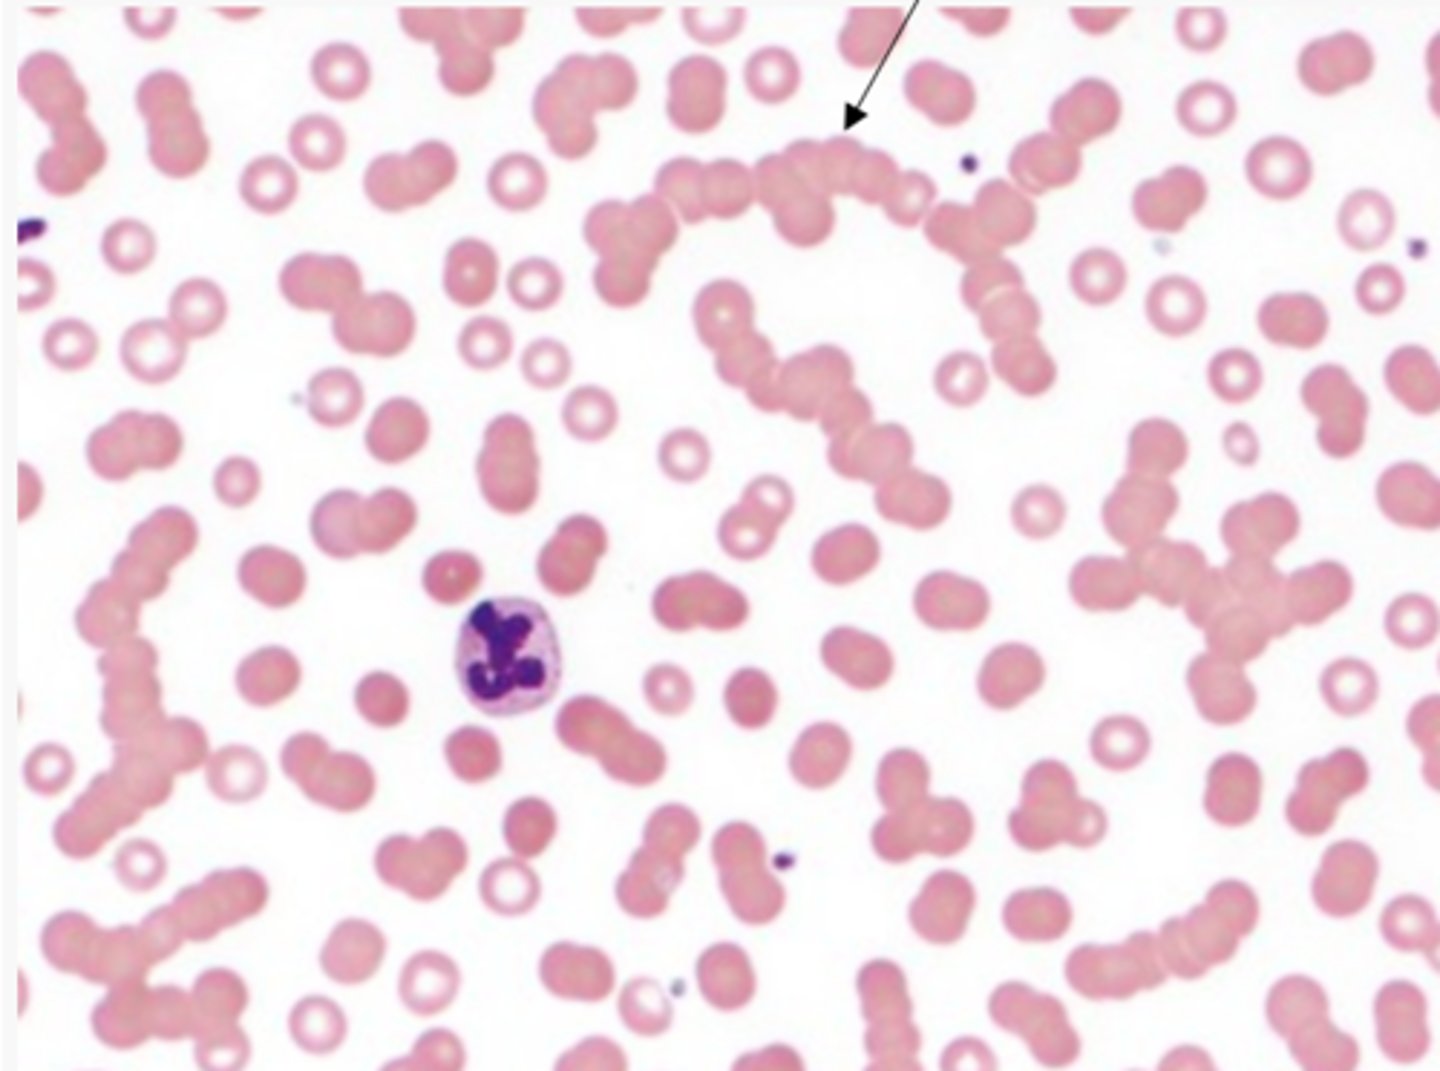
<p>What causes rouleaux formations?</p>
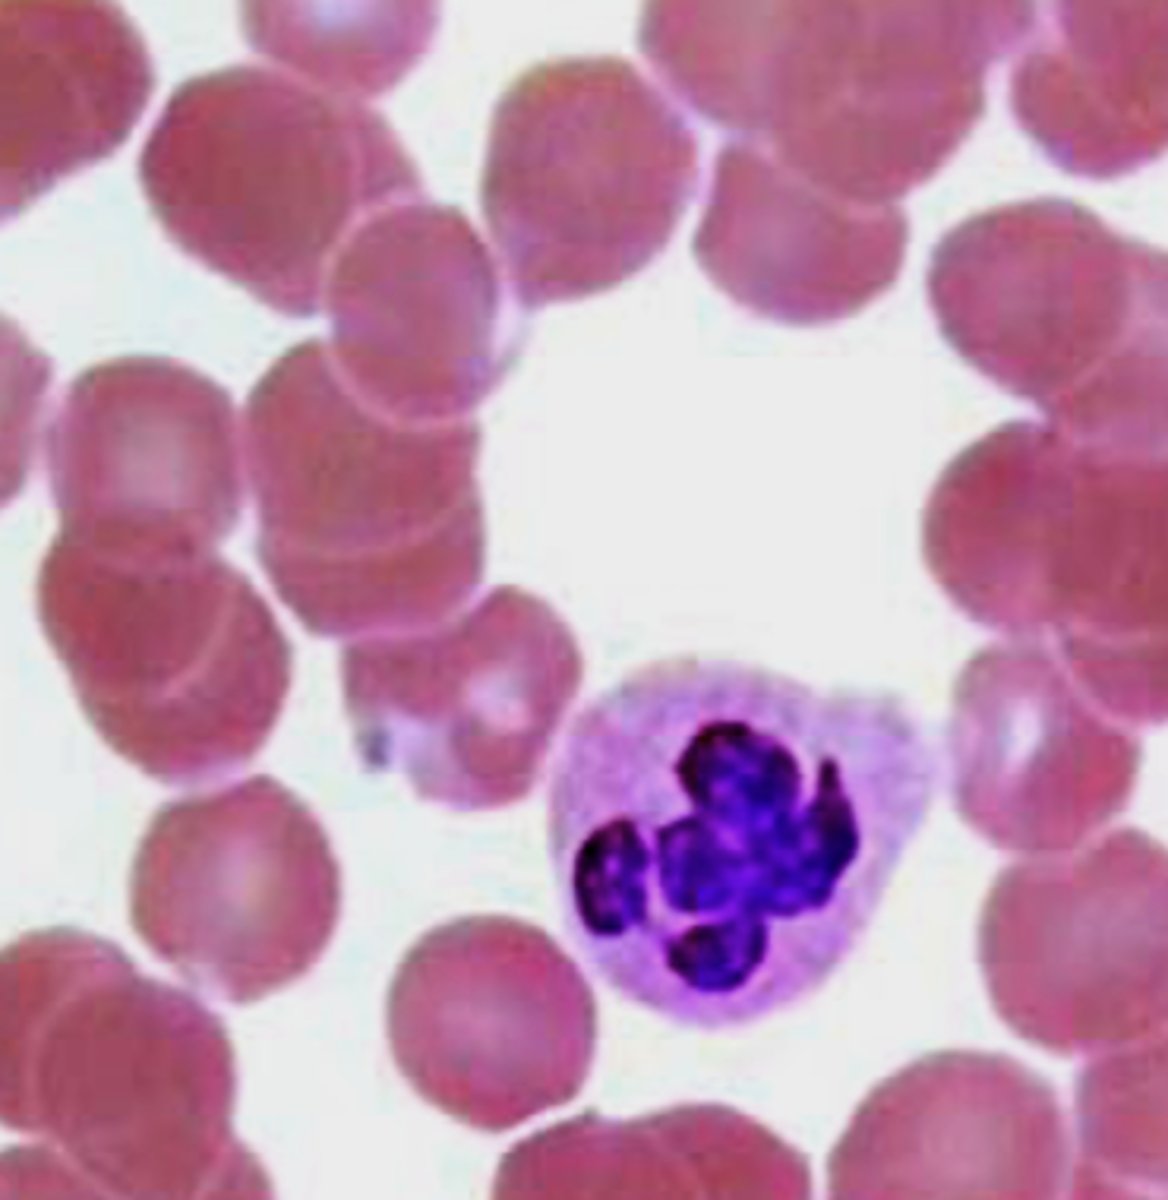
<p>Which leukocyte?</p>
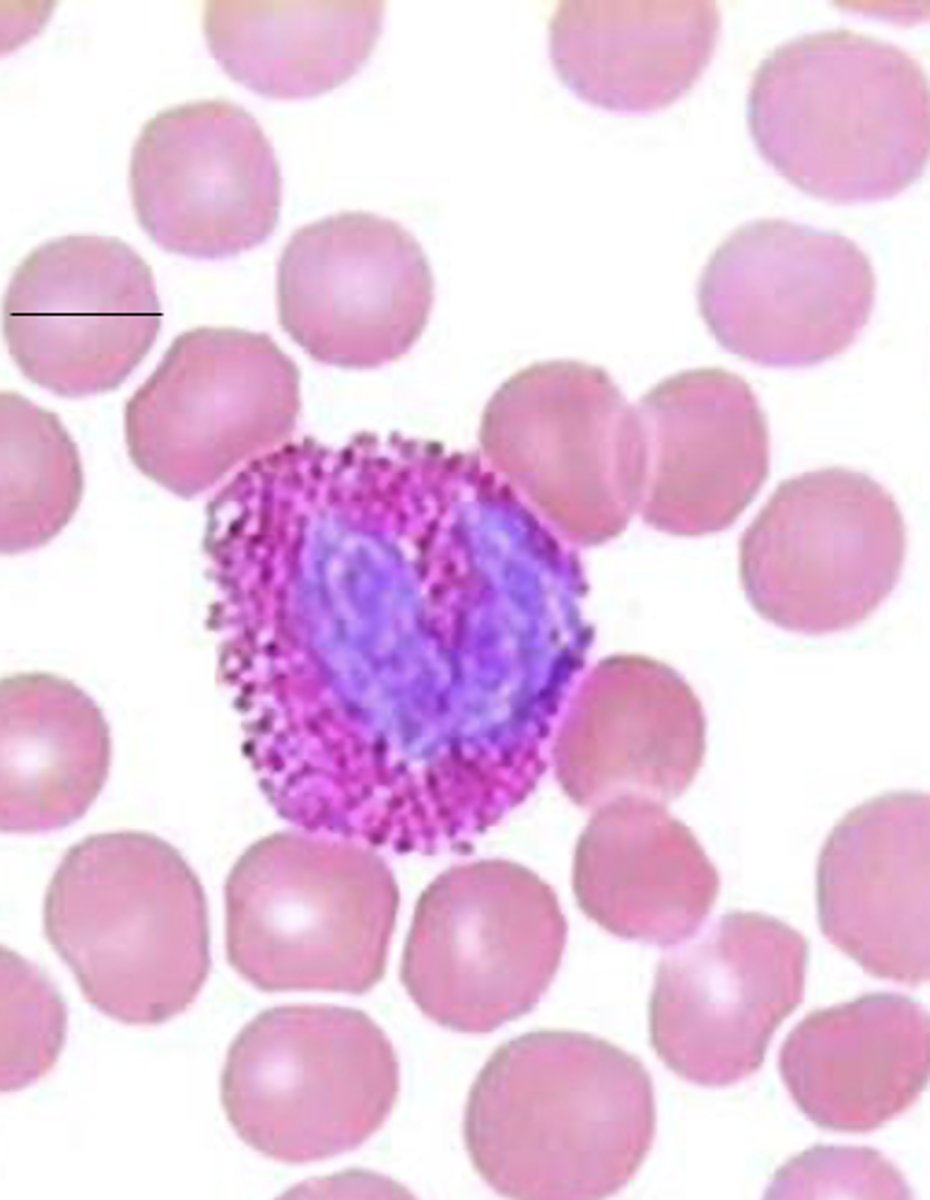
<p>Which leukocyte?</p>
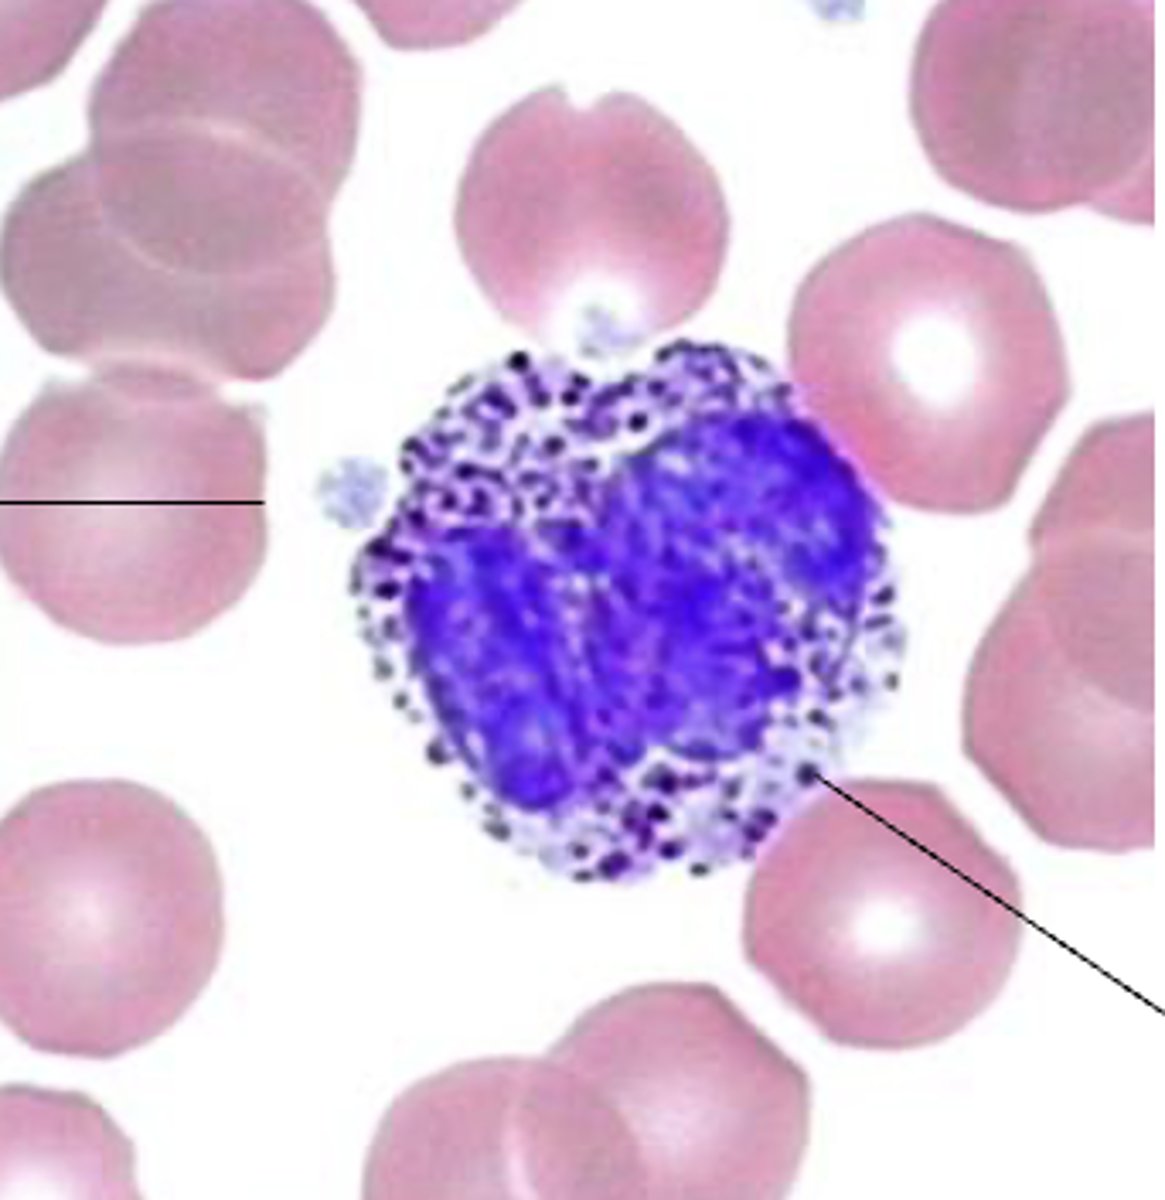
<p>Which leukocyte?</p>

1/127
Looks like no tags are added yet.
Name | Mastery | Learn | Test | Matching | Spaced | Call with Kai |
|---|
No analytics yet
Send a link to your students to track their progress
extracellular fluid matrix
What component of blood is plasma found in?
plasma
What contains albumin, globulin and fibrinogen?
erythrocytes
What type of cells are RBCs?
leukocytes
What type of cells are WBCs?
platelets
What are cell fragments?
B, C
Identify the correct statement(s)
A) Hematocrit is the percentage of volume of packed leukocyte in a sample of blood
B) A low level of hematocrit indicates anemia
C) Arrow indicates where platelets are
D) White blood cells and red blood cells are pooled at the bottom
E) The bottom portion is the plasma, which contains water, proteins, or enzymes

orange
Which color are the platelets in?

hematocrit
Define the following:
Volume of packed erythrocytes in a sample of blood
hematocrit
A low level of ___________ can indicate anemia
plasma
What is in the yellow section?

Red blood cells
What is in the red section?

polycythemia
What condition is too many RBCs?
anemia
What condition is low RBCs?
blood smear
How are blood cells viewed?
romanowsky
What stains a mixture of acidic and basic dyes?
Romanowsky stain
What type of stain?
romanowsky staining
What type of stain can be red, gray-blue/blue, violet purple and purple?
Red (orthochromasia-acidic only)
What color romanowsky stain are erythrocytes and eosinophil granules?
Gray-blue/blue (orthochromasia-basic only)
What color romanowsky stain are the cytoplasm of monocytes or lymphocytes?
violet purple (metachromasia-color shift from basic blue to violet purple)
What color romanowsky stain are basophil granules?
purple (polychromasia-layered with basic and acidic)
What color romanowsky stain are azurophilic granules, neutrophil granules, chromatin (nucleus) and platelets?
Metachromasia
What can happen with only certain basic dyes (e.g. toluidine blue, methylene blue) and can happen to any cell or tissues with abundant negative charges: such as cartilage, mast cells?
metachromasia
What kind of romanosky stain?

Polyion presence
Define the following:
When stained with a concentrated basic dye, the dye molecules are sufficiently close to form dimeric and polymeric aggregates---causing a shift in absorption properties
polychromasia
What kind of romanowsky stain?

polychromasia
What dye involves 2 dyes?
purple result (complex formation of red and blue dyes)
In Romanowsky staining, in which acidic (red) and basic (blue) dyes are used together, polychromasia means:
D) Resulting purple color caused by the complex formation of red and blue dyes
In Romanosky staining, in which acidic (red) and basic (blue) dyes are used together, polychromasia means:
A) Some cels are stained red, some blue, and some white (unstained)
B) Different sub-cellular structures of the same cell have different colors
C) A shift of the color of the basic dye
D) Resulting purple color caused by the complex formation of red and blue dyes

A) Live approximately 12 months
Which one of the following INCORRECTLY describes red blood cells?
A) Live approximately 12 months
B) Old and diseased RBCs are usually cleared in the spleen
C) Their predecessors, reticulocytes, possess some basophilia due to the still-present ribosomes
D) Biconcave discs, approximately 7.5μM in diameter
E) Stacks of them are called Rouleaux formations
F) Highly flexible when healthy
120 days
How long do RBCs usually live?
spleen
old and diseased RBCs are usually cleared where?
biconcave disc (increases surface area)
What is the shape of RBCs?
7.5 µM (diameter)
How big are RBCs?
True
T/F: RBCs are highly flexible when healthy
Reticulocytes
What are immature RBCs?
stem cells in red bone marrow
What are reticulocytes derived from before they shed their nucleus and cell organelles?
Mature erythrocyte
ID the blue box:

Reticulocyte
ID the red box:

orthochromasia
What type of staining is shown in the mature erythrocyte (blue)?

polychromasia (basophilia)
What type of staining is shown in the mature reticulocyte (red)?

hypertonic
In what type of solution do RBCs become spiky? (aka: Crenation)

Crenation
an erythrocyte placed in a hypertonic solution will result in __________ and becomes spiky
Sickle Cell Anemia
A mutation in hemoglobin from Glu to Val causes what disease?
distorts appearance to sickle-like shape
What does sickle cell anemia cause?
Malaria; Low oxygen, aggregate, premature rupture, parasite unable to reproduce
What are sickle cells resistant to? Why?
sickle cell anemia (cells cannot get through blood vessels easily)
What disease is caused by the abnormal cells?
Rouleaux formations
What are stacks of RBCs called?
Could be caused by: inflammation, infection, cancer, increase in proteins (immunoglobulins and fibrinogen during viral infections)
What causes rouleaux formations?
3-8%
What percentage of leukocyte distribution are monocytes?
50-70%
What percentage of leukocyte distribution are neutrophils?
2-4%
What percentage of leukocyte distribution are eosinophils?
0.5-1%
What percentage of leukocyte distribution are basophils?
20-40%
What percentage of leukocyte distribution are lymphocytes?
neutrophils
Which leukocyte is the most abundant?
WBCs
Leukocytes are also known as __________
granulocytes
Neutrophils, eosinophils, and basophils are all what?
agranulocytes
Lymphocytes and monocytes are what?
neutrophil
Which leukocyte?
2-5 lobes (polychromatic)
What is the structure of the nucleus of neutrophils?
3 types (polychromatic)
How many types of granules do neutrophils have?
neutrophils
Azurophilic (lysosomes), specific (bactericidal enzymes), anti-bacteria factors, including those that prevent bacteria migration are granules for which leukocyte?
phagocytic, bactericidal (attracted to chemokines)
What is the function of neutrophils?
neutrophil, barr body
What cell is this? What structure are the right arrow and circle highlighting?

Females (X-inactivatation)
Do males or females have barr bodies?
10-12 uM
How big is a neutrophil?
eosinophils
Which leukocyte?
2 lobes (polychromatic)
What is the structure of the nucleus of eosinophils?
eosinophil
Which leukocyte?
Lysosomal hydrolases and _____________-specific protein, including major basic protein, _____________ cationic protein and eoneurotoxin (toxic to protozoans and parasites)
anti-parasitic, allergy (arylsulfatase and histaminase modulate allergic response)
What is the function of eosinophils?
eosinophil
What leukocyte?

crystalline body, eosinophils
What are the small circular structures-which leukocyte do they belong to?

basophil
Which leukocyte?
basophil
Which cell is the least abundant?
2 lobes (polychromatic)
What is the structure of the nucleus of basophils?
basophils
Which leukocyte has these types of granules?
1. Specific: contain histamine, and are very rich in glycosaminoglycan, which gives intense stainings (metachromasia)
2. Azurophilic (lysosomes)
allergic and parasitic reactions
What is the function of a basophil?
basophil
Which cell?

basophils (nucleus often masked by large and abundant granules)
Which cell?

spherical or oval (polychromatic)
What is the structure of the nucleus of lymphocytes?
orthochromatic (rough ER, with RNA, basophilic)
How does the cytoplasm of lymphocytes stain?
- B cells
- T cells
What are the small types of lymphocytes?
granular cells (natural killer cells)
What are the large types of lymphocytes?
acquired immunity (cell-mediated defense, antibody production)
What is the function of lymphocytes?
lymphocyte (agranulocyte)
What type of cell?

B lymphocyte-derived plasma cell
What cell was used for COVID 19 treatment?

lymphocyte
What cell?

lymphocyte (nucleus-often occupying majority of cell, thin cytoplasm)
What cell is this?

folded, u-shaped (polychromatic)
What is the structure of the nucleus of monocytes?
mostly orthochromatic (w/ fine azurophilic granules)
How does the cytoplasm of monocytes stain?
precursor for mononuclear phagocyte system
What is the function of monocytes?
Monocytes
What is the largest peripheral blood cell?
monocyte
What cell?

monocyte (large in cell size, nucleus shaped like a kidney bean)
What cell?

liver
Where are kupffer cells located?
lungs
Where are alveolar macrophages located?
- CT
- Spleen
- Lymph nodes
- Bone marrow
- Thymus
Where are macrophages located?
Bone
Where are osteoclasts located?
epidermis
Where are langerhan's cells located?
B) It typically has two nuclei
Which statement is NOT TRUE regarding this cell?
A) It is a granulocyte
B) It typically has two nuclei
C) It fights against parasites
D) Its granules are characterized by the crystalline bodies

A, C
Which of the following is FALSE about basophils? (Can be more than one)
A) They are the most abundant white blood cell in peripheral blood
B) They exhibit metachromasia in Romanowsky staining
C) They have abundant eosinophilic crystalline bodies that are released upon infection
D) They store abundant histamine in the granules
